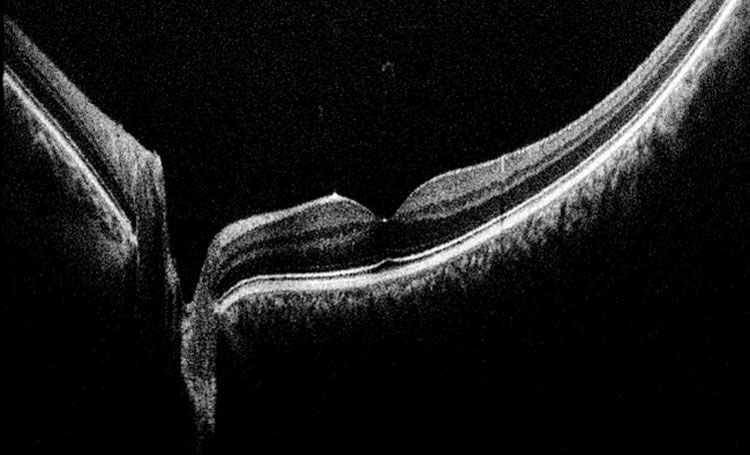

EnFocus Ultra-HD OCT technology delivers high definition real-time images of both the posterior and anterior segment. The EnFocus Ultra-HD OCT includes fine axial resolution ≤ 4 μm coupled with high OCT scan density (up to 1 million A-scans per volume).
The best images matter. The EnFocus Ultra-HD allows you to see in high definition at 2.5 mm image depth in tissue. Fine resolution, subsurface intrasurgical OCT images may aid in the visualization of physiological and pathological conditions of the eye during surgery.
EnFocus Ultra-HD OCT, 16 mm lateral scan of retina
EnFocus Ultra-HD OCT
FDA 510(k) Cleared
The EnFocus Ultra-Deep OCT option delivers very deep imaging, up to 11 mm depth in tissue, with > 20 mm scan length. Full anterior segment views are achieved. Anterior structures continue to be resolved with detail to ≤ 9 μm.
EnFocus Ultra-Deep OCT

EnFocus Ultra-Deep OCT image of full anterior segment
The EnFocus design is validated to meet optical power safety standards. The optical exposure, with center wavelength at 880 nm, is less than 750 μW.
FDA 510(k) Cleared

InVivoVue OCT image management software provides intuitive surgical planning and workflow management.
Easy-to-use InVivoVue OCT image management software provides intuitive surgical planning and workflow management.
FDA 510(k) Cleared

EnFocus preserves normal surgical working distance of the existing microscope through the use of 175 mm and 200 mm objective lenses. With a small increase to stack height, adjustment of the angle of the low profile oculars may be made to provide comfortable viewing for the surgeon.
The EnFocus OCT is compatible with common fundus viewing systems, which are easily attached to a dovetail mount.
FDA 510(k) Cleared

EnFocus captures the highest resolution images and then displays this high density information in rich detail on the EnFocus large format external LCD.
Real-time OCT B-scan images, OCT volume intensity projections, and microscope camera images are easy-to-see and use during surgery.
FDA 510(k) Cleared

The EnFocus was designed for intrasurgical imaging. The unique objective delivery design injects the OCT signal below the optics carrier, and not through the microscope oculars. This design maximizes OCT image performance.
The EnFocus objective delivery design enables:
FDA 510(k) Cleared
Hiện tại chưa có ý kiến đánh giá nào về sản phẩm. Hãy là người đầu tiên chia sẻ cảm nhận của bạn.